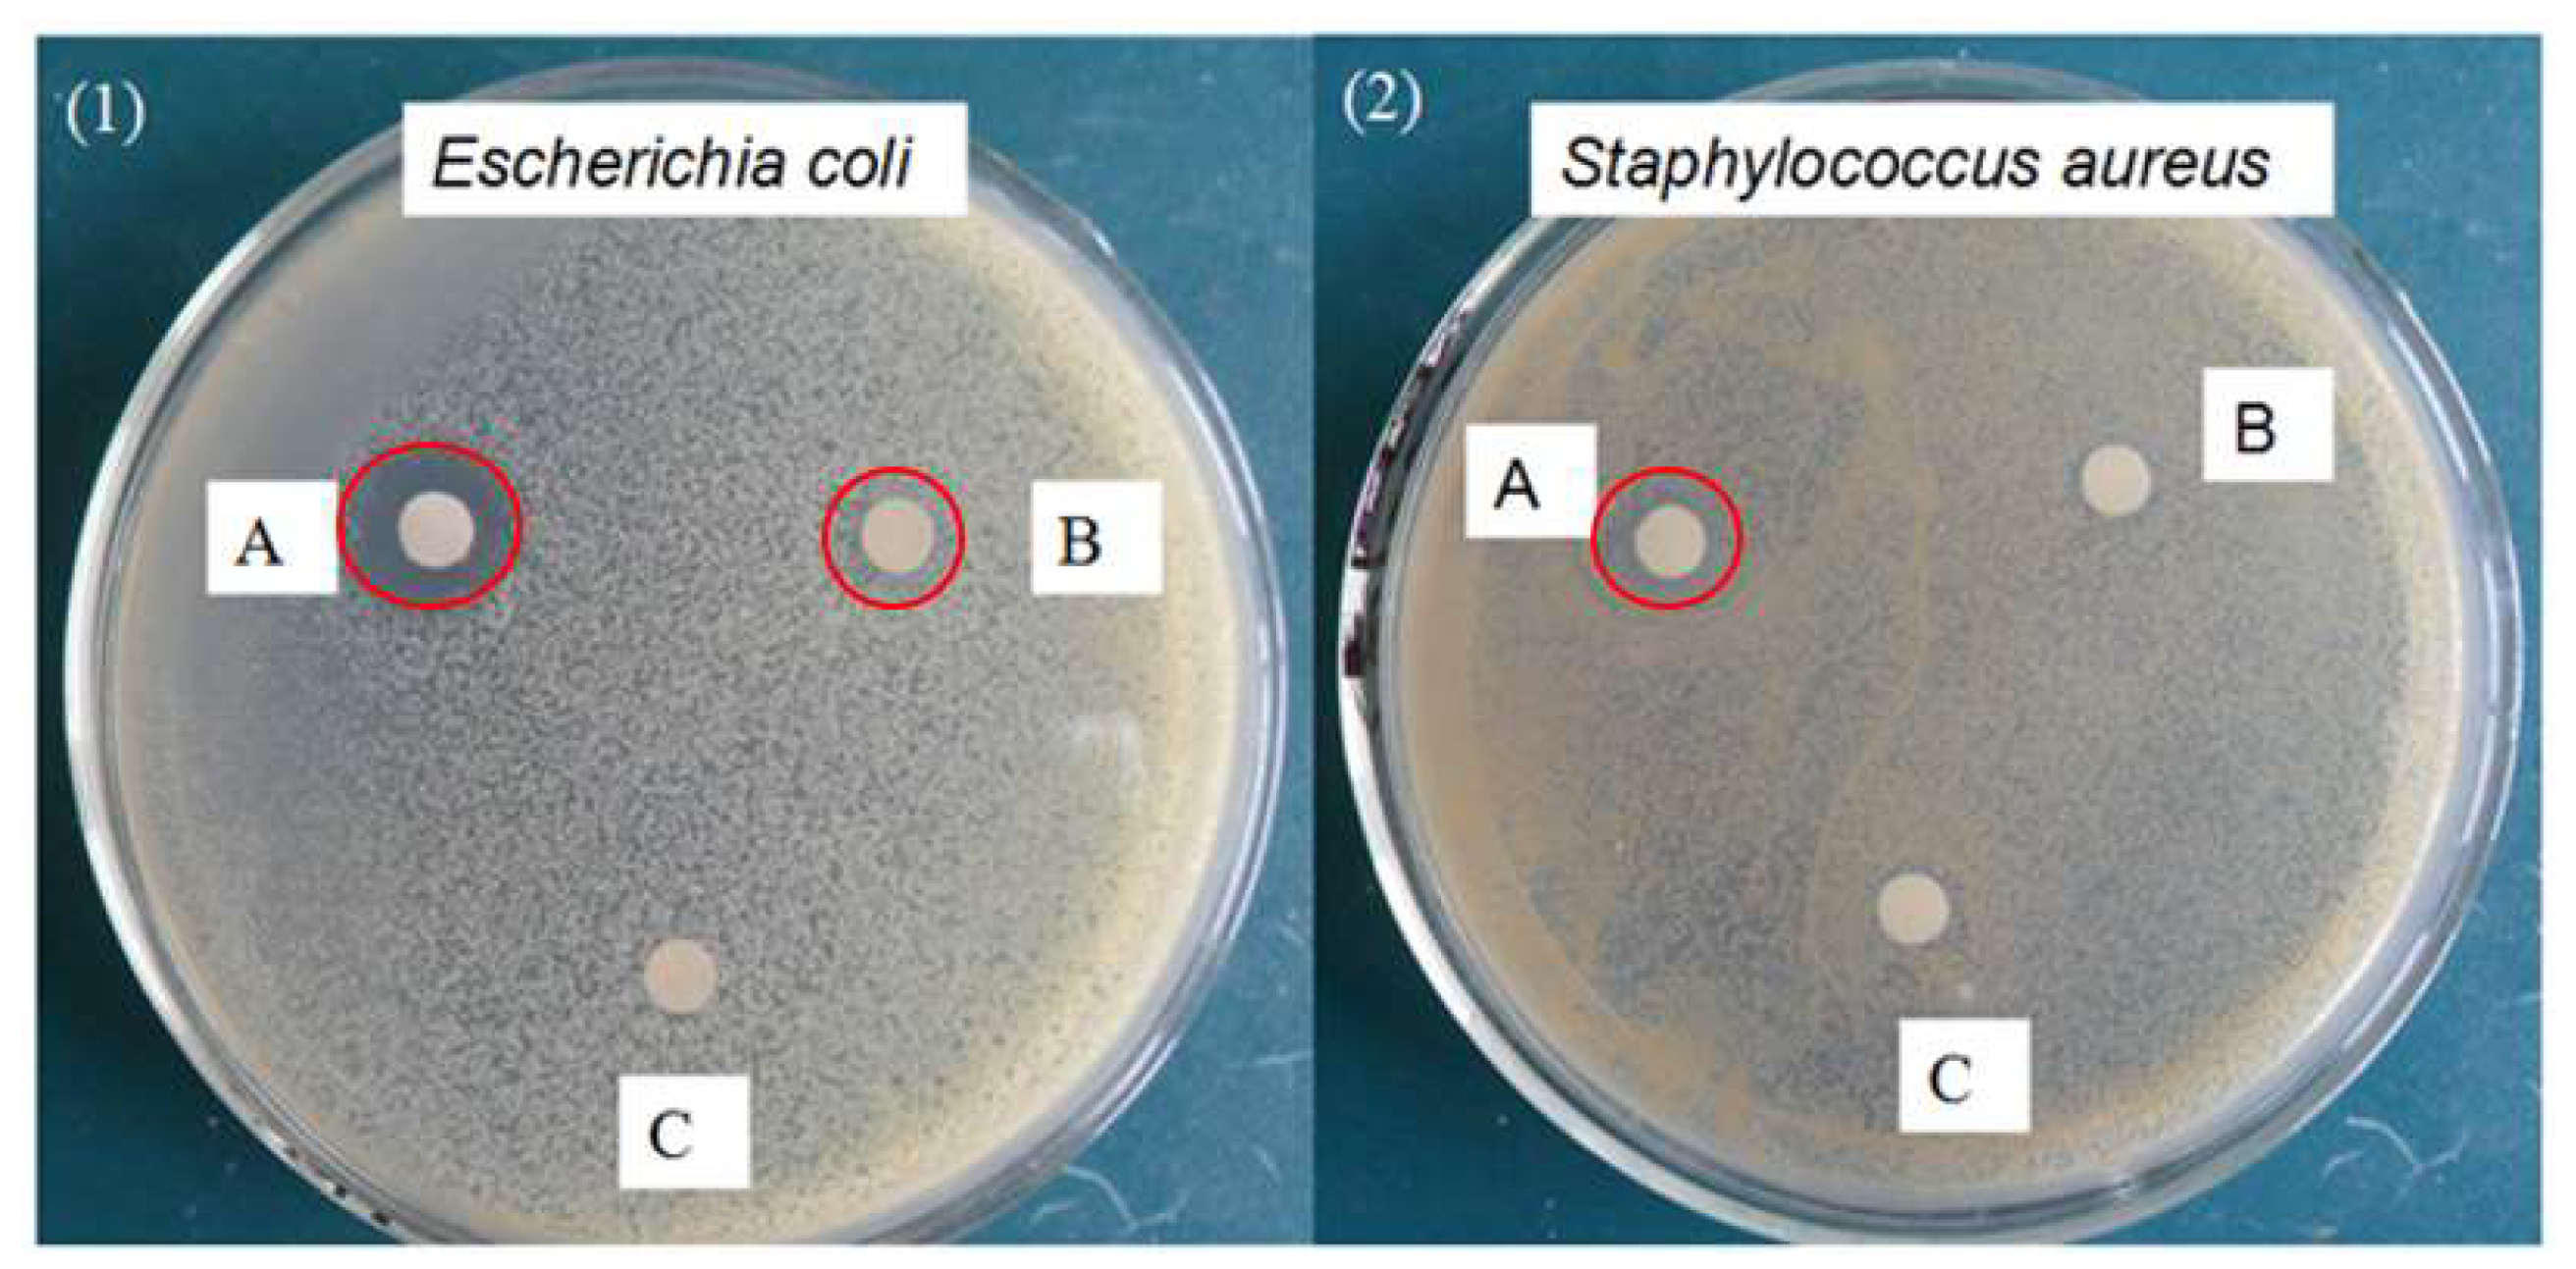
Water 13 03561 g007 550

Synergistic Degradation of Chloramphenicol by an Ultrasound-Enhanced Fenton-like Sponge Iron System
Abstract
:1. Introduction
2. Materials and Methods
2.1. Materials
2.2. Procedure
2.3. Analytical Methods
2.3.1. Sponge Iron Characterization
2.3.2. Sponge Iron Recyclability Experiment
2.3.3. CAP Concentration
2.3.4. Total Organic Carbon Investigation
2.3.5. Antibacterial Activity Test
2.3.6. Product Identification
3. Results and Discussion
3.1. Degradation of CAP by Different Processes
3.2. Effect of Initial pH Variation
3.3. Effect of Hydrogen Peroxide Concentration
3.4. Effect of Sponge Iron Concentration
3.5. Process Optimization
1.0200X1X2 − 0.60000X1X3 − 0.092500X2X3 + 1.47100X12 − 2.95475X22 − 5.58975X32
3.6. Effect of Presence of Inorganic Salts and RECYCLABILITY Experiments
3.7. Mineralization of CAP
3.8. Antibacterial Activity Test
3.9. CAP Degradation Pathway during US/Fenton-like Treatment
4. Conclusions
Author Contributions
Funding
Institutional Review Board Statement
Informed Consent Statement
Data Availability Statement
Acknowledgments
Conflicts of Interest
References
- Yin, F.; Dong, H.; Zhang, W.; Zhu, Z.; Shang, B.; Wang, Y. Removal of combined antibiotic (florfenicol, tylosin and tilmicosin) during anaerobic digestion and their relative effect. Renew. Energy 2019, 139, 895–903. [Google Scholar] [CrossRef]
- Klauson, D.; Krichevskaya, M.; Borissova, M.; Preis, S. Aqueous photocatalytic oxidation of sulfamethizole. Environ. Technol. 2010, 31, 1547–1555. [Google Scholar] [CrossRef]
- Shukla, P.; Bansode, F.; Singh, R. Chloramphenicol toxicity: A review. J. Med. Med. Sci. 2013, 2, 1313–1316. [Google Scholar]
- Wu, G.; Kong, W.; Gao, Y.; Kong, Y.; Dai, Z.; Dan, H.; Shang, Y.; Wang, S.; Yin, F.; Yue, Q.; et al. Removal of chloramphenicol by sulfide-modified nanoscale zero-valent iron activated persulfate: Performance, salt resistance, and reaction mechanisms. Chemosphere 2021, 286, 131876. [Google Scholar] [CrossRef]
- Wu, Y.; Mao, S.; Liu, C.; Pei, F.; Wang, F.; Hao, Q.; Xia, M.; Lei, W. Enhanced degradation of chloramphenicol through peroxymonosulfate and visible light over z-scheme photocatalysts: Synergetic performance and mechanism insights. J. Colloid Interface Sci. 2022, 608, 322–333. [Google Scholar] [CrossRef] [PubMed]
- Shokri, M.; Jodat, A.; Modirshahla, N.; Behnajady, M.A. Photocatalytic degradation of chloramphenicol in an aqueous suspension of silver-doped tio2 nanoparticles. Environ. Technol. 2013, 34, 1161–1166. [Google Scholar] [CrossRef]
- Ioannou-Ttofa, L.; Raj, S.; Prakash, H.; Fatta-Kassinos, D. Solar photo-fenton oxidation for the removal of ampicillin, total cultivable and resistant e-coli and ecotoxicity from secondary-treated wastewater effluents. Chem. Eng. J. 2019, 355, 91–102. [Google Scholar] [CrossRef]
- Kaur, A.; Umar, A.; Kansal, S.K. Heterogeneous photocatalytic studies of analgesic and non-steroidal anti-inflammatory drugs. Appl. Catal. A-Gen. 2016, 510, 134–155. [Google Scholar] [CrossRef]
- Xia, Q.; Zhang, D.; Yao, Z.; Jiang, Z. Investigation of cu heteroatoms and cu clusters in fe-cu alloy and their special effect mechanisms on the fenton-like catalytic activity and reusability (vol 299, 120662, 2021). Appl. Catal. B-Environ. 2022, 299, 120662. [Google Scholar] [CrossRef]
- Gao, L.; Cao, Y.; Wang, L.; Li, S. A review on sustainable reuse applications of fenton sludge during wastewater treatment. Front. Environ. Sci. Eng. 2022, 16, 77. [Google Scholar] [CrossRef]
- Sharma, A.; Verma, M.; Haritash, A.K. Degradation of toxic azo dye (ao7) using fenton’s process. Adv. Environ. Res. 2016, 5, 189–200. [Google Scholar] [CrossRef]
- Sun, S.; Hu, Y.; Xu, M.; Cheng, F.; Zhang, H.; Li, Z. Photo-fenton degradation of carbamazepine and ibuprofen by iron-based metal-organic framework under alkaline condition. J. Hazard. Mater. 2022, 424, 127698. [Google Scholar] [CrossRef]
- Munoz, M.; de Pedro, Z.M.; Casas, J.A.; Rodriguez, J.J. Preparation of magnetite-based catalysts and their application in heterogeneous fenton oxidation-A review. Appl. Catal. B-Environ. 2015, 176, 249–265. [Google Scholar] [CrossRef] [Green Version]
- Xie, H.-N.; Li, J.; Wang, Y.-E.; Zhao, W.; Zhang, L.-H.; Li, J. Influencing factors for the fenton-like of biological sponge iron system and its degradation mechanism of aniline. Process Biochem. 2021, 101, 230–236. [Google Scholar] [CrossRef]
- Zhang, T.T.; Yang, Y.L.; Gao, J.F.; Li, X.; Yu, H.K.; Wang, N.; Du, P.; Yu, R.; Li, H.; Fan, X.Y.; et al. Synergistic degradation of chloramphenicol by ultrasound-enhanced nanoscale zero-valent iron/persulfate treatment. Sep. Purif. Technol. 2020, 240, 116575. [Google Scholar] [CrossRef]
- Ninomiya, K.; Takamatsu, H.; Onishi, A.; Takahashi, K.; Shimizu, N. Sonocatalytic–fenton reaction for enhanced oh radical generation and its application to lignin degradation. Ultrason. Sonochem. 2013, 20, 1092–1097. [Google Scholar] [CrossRef]
- Zou, X.; Zhou, T.; Mao, J.; Wu, X. Synergistic degradation of antibiotic sulfadiazine in a heterogeneous ultrasound-enhanced fe0/persulfate fenton-like system. Chem. Eng. J. 2014, 257, 36–44. [Google Scholar] [CrossRef]
- Guo, J.; Zhu, L.; Sun, N.; Lan, Y. Degradation of nitrobenzene by sodium persulfate activated with zero-valent zinc in the presence of low frequency ultrasound. J. Taiwan Inst. Chem. Eng. 2017, 78, 137–143. [Google Scholar] [CrossRef]
- Shen, S.; Zhou, C.; Zeng, Y.; Zhang, H.; Hossen, M.A.; Dai, J.; Li, S.; Qin, W.; Liu, Y. Structures, physicochemical and bioactive properties of polysaccharides extracted from panax notoginseng using ultrasonic/microwave-assisted extraction. LWT 2022, 154, 112446. [Google Scholar] [CrossRef]
- Anacona, J.R.; Estacio, J. Synthesis and antibacterial activity of cefotaxime metal complexes. J. Transit. Met. Chem. 2005, 31, 227–231. [Google Scholar] [CrossRef]
- Liu, Y.; Wang, X.K.; Chen, B.; Wang, C.; Shen, T.T. Degradation of azo dye c.I. Reactive blue 194 in water by sponge iron in the presence of ultrasound. Environ. Eng. Sci. 2014, 31, 541–547. [Google Scholar] [CrossRef]
- de Luna, M.D.G.; Colades, J.I.; Su, C.C.; Lu, M.C. Comparison of dimethyl sulfoxide degradation by different fenton processes. Chem. Eng. J. 2013, 232, 418–424. [Google Scholar] [CrossRef]
- Gode, J.N.; Souza, D.H.; Trevisan, V.; Skoronski, E. Application of the fenton and fenton-like processes in the landfill leachate tertiary treatment. J. Environ. Chem. Eng. 2019, 7, 103352. [Google Scholar] [CrossRef]
- Ferkous, H.; Merouani, S.; Hamdaoui, O.; Petrier, C. Persulfate-enhanced sonochemical degradation of naphthol blue black in water: Evidence of sulfate radical formation. Ultrason. Sonochem. 2017, 34, 580–587. [Google Scholar] [CrossRef] [PubMed]
- Nie, M.H.; Yang, Y.; Zhang, Z.J.; Yan, C.X.; Wang, X.N.; Li, H.J.; Dong, W.B. Degradation of chloramphenicol by thermally activated persulfate in aqueous solution. Chem. Eng. J. 2014, 246, 373–382. [Google Scholar] [CrossRef]
- Lucas, M.S.; Peres, J.A. Decolorization of the azo dye reactive black 5 by fenton and photo-fenton oxidation. Dye. Pigment. 2006, 71, 236–244. [Google Scholar] [CrossRef]
- Xu, X.-R.; Li, X.-Z. Degradation of azo dye orange g in aqueous solutions by persulfate with ferrous ion. Sep. Purif. Technol. 2010, 72, 105–111. [Google Scholar] [CrossRef] [Green Version]
- Stefánsson, A. Iron(iii) hydrolysis and solubility at 25 °C. Environ. Sci. Technol. 2007, 41, 6117–6123. [Google Scholar] [CrossRef]
- Nidheesh, P.V.; Rajan, R. Removal of rhodamine b from a water medium using hydroxyl and sulphate radicals generated by iron loaded activated carbon. RSC Adv. 2016, 6, 5330–5340. [Google Scholar] [CrossRef]
- Verma, M.; Haritash, A.K. Degradation of amoxicillin by fenton and fenton-integrated hybrid oxidation processes. J. Environ. Chem. Eng. 2019, 7, 102886. [Google Scholar] [CrossRef]
- Ay, F.; Kargi, F. Advanced oxidation of amoxicillin by fenton’s reagent treatment. J. Hazard. Mater. 2010, 179, 622–627. [Google Scholar] [CrossRef]
- Tian, J.N.; Sharshar, M.M.; Yang, M.H.; Mu, T.Z.; Xing, J.M. Degradation of rhodamine b at neutral ph using modified sponge iron as a heterogeneous electro-fenton catalyst. Environ. Prog. Sustain. Energy 2018, 37, 989–995. [Google Scholar] [CrossRef]
- Liu, Z.; Xu, D.; Xia, N.; Zhao, X.; Kong, F.; Wang, S.; Fatehi, P. Preparation and application of phosphorylated xylan as a flocculant for cationic ethyl violet dye. Polymers 2018, 10, 317. [Google Scholar] [CrossRef] [Green Version]
- Sujatha, S.; Sivarethinamohan, R. Application of response surface methodology to optimize lead(ii) ion adsorption by activated carbon fabricated from de oiled soya. Desalin. Water Treat. 2021, 226, 242–250. [Google Scholar] [CrossRef]
- Jeong, S.Y.; Lee, J.W. Optimization of pretreatment condition for ethanol production from oxalic acid pretreated biomass by response surface methodology. Ind. Crop. Prod. 2016, 79, 1–6. [Google Scholar] [CrossRef]
- Solhi, L.; Sun, H.S.; Daswani, S.H.; Shojania, S.; Springate, C.M.K.; Brumer, H. Controlled sulfation of mixed-linkage glucan by response surface methodology for the development of biologically applicable polysaccharides. Carbohydr. Polym. 2021, 269, 118275. [Google Scholar] [CrossRef] [PubMed]
- Dong, X.; Gao, X.; Song, J.; Zhao, L. A novel dispersive magnetic solid phase microextraction using ionic liquid-coated amino silanized magnetic graphene oxide nanocomposite for high efficient separation/preconcentration of toxic ions from shellfish samples. Food Chem. 2021, 360, 130023. [Google Scholar] [CrossRef]
- Liu, Z.M.; Xu, D.D.; Kong, F.G.; Wang, S.J.; Yang, G.H.; Fatehi, P. Preparation and application of sulfated xylan as a flocculant for dye solution. Biotechnol. Prog. 2018, 34, 529–536. [Google Scholar] [CrossRef]
- Wang, S.; Wang, J. Trimethoprim degradation by fenton and fe(ii)-activated persulfate processes. Chemosphere 2018, 191, 97–105. [Google Scholar] [CrossRef] [PubMed]
- Nie, M.; Yan, C.; Xiong, X.; Wen, X.; Yang, X.; Lv, Z.; Dong, W. Degradation of chloramphenicol using a combination system of simulated solar light, fe2+ and persulfate. Chem. Eng. J. 2018, 348, 455–463. [Google Scholar] [CrossRef]
- Csay, T.; Rácz, G.; Takács, E.; Wojnárovits, L. Radiation induced degradation of pharmaceutical residues in water: Chloramphenicol. Radiat. Phys. Chem. 2012, 81, 1489–1494. [Google Scholar] [CrossRef]

| Run | X1 | X2 | X3 | pH | H2O2, mmol/L | Fe, g/L | Degradation |
|---|---|---|---|---|---|---|---|
| (X1) | (X2) | (X3) | (%) | ||||
| 1 | −1 | −1 | 0 | 2 | 2 | 2 | 90.45 |
| 2 | 1 | −1 | 0 | 3 | 2 | 2 | 95.33 |
| 3 | −1 | 1 | 0 | 2 | 4 | 2 | 94.84 |
| 4 | 1 | 1 | 0 | 3 | 4 | 2 | 97.68 |
| 5 | −1 | 0 | −1 | 2 | 3 | 1 | 86.46 |
| 6 | 1 | 0 | −1 | 3 | 3 | 1 | 91 |
| 7 | −1 | 0 | 1 | 2 | 3 | 3 | 93.48 |
| 8 | 1 | 0 | 1 | 3 | 3 | 3 | 96.82 |
| 9 | 0 | −1 | −1 | 2.5 | 2 | 1 | 83.6 |
| 10 | 0 | 1 | −1 | 2.5 | 4 | 1 | 87.14 |
| 11 | 0 | −1 | 1 | 2.5 | 2 | 3 | 90.28 |
| 12 | 0 | 1 | 1 | 2.5 | 4 | 3 | 93.45 |
| 13 | 0 | 0 | 0 | 2.5 | 3 | 2 | 97.16 |
| 14 | 0 | 0 | 0 | 2.5 | 3 | 2 | 97.14 |
| 15 | 0 | 0 | 0 | 2.5 | 3 | 2 | 97.15 |
| 16 | 0 | 0 | 0 | 2.5 | 3 | 2 | 97.18 |
| 17 | 0 | 0 | 0 | 2.5 | 3 | 2 | 97.18 |
| Source | Sum of Squares | Degrees of Freedom | Mean Square | F-Value | p-Value |
|---|---|---|---|---|---|
| Model | 314.04 | 9 | 34.89 | 32,985.13 | <0.0001 |
| X1-pH | 30.42 | 1 | 30.42 | 28,756.25 | <0.0001 |
| X2-H2O2 | 22.61 | 1 | 22.61 | 21,376.06 | <0.0001 |
| X3-Fe | 83.4 | 1 | 83.4 | 78,837.31 | <0.0001 |
| X1X2 | 1.04 | 1 | 1.04 | 983.5 | <0.0001 |
| X1X3 | 0.36 | 1 | 0.36 | 340.31 | <0.0001 |
| X2X3 | 0.034 | 1 | 0.034 | 32.35 | 0.0007 |
| X12 | 0.57 | 1 | 0.57 | 538.29 | <0.0001 |
| X22 | 36.76 | 1 | 36.76 | 34,749.68 | <0.0001 |
| X32 | 131.56 | 1 | 131.56 | 124,400 | <0.0001 |
| Lack of Fit | 0.00061 | 3 | 0.0002 | 6.38 | 0.0527 |
| Pure error | 0.00013 | 4 | 0.0032 |
| Bacterial Strains | Zone of Inhibition (mm) * | ||
|---|---|---|---|
| A: Initial CAP | B: CAP after Degraded by 50% | C: CAP after Degraded by 99% | |
| Gram negative: | 15 | 9 | N |
| Escherichia coli | |||
| Gram positive: | 10 | N | N |
| Staphylococcus aureus | |||
Publisher’s Note: MDPI stays neutral with regard to jurisdictional claims in published maps and institutional affiliations. |
© 2021 by the authors. Licensee MDPI, Basel, Switzerland. This article is an open access article distributed under the terms and conditions of the Creative Commons Attribution (CC BY) license (https://creativecommons.org/licenses/by/4.0/).
Share and Cite
Meng, X.; Liu, Z.; Wang, S.; Kong, F. Synergistic Degradation of Chloramphenicol by an Ultrasound-Enhanced Fenton-like Sponge Iron System. Water 2021, 13, 3561. https://doi.org/10.3390/w13243561
Meng X, Liu Z, Wang S, Kong F. Synergistic Degradation of Chloramphenicol by an Ultrasound-Enhanced Fenton-like Sponge Iron System. Water. 2021; 13(24):3561. https://doi.org/10.3390/w13243561
Chicago/Turabian StyleMeng, Xia, Zhongming Liu, Shoujuan Wang, and Fangong Kong. 2021. "Synergistic Degradation of Chloramphenicol by an Ultrasound-Enhanced Fenton-like Sponge Iron System" Water 13, no. 24: 3561. https://doi.org/10.3390/w13243561
APA StyleMeng, X., Liu, Z., Wang, S., & Kong, F. (2021). Synergistic Degradation of Chloramphenicol by an Ultrasound-Enhanced Fenton-like Sponge Iron System. Water, 13(24), 3561. https://doi.org/10.3390/w13243561

